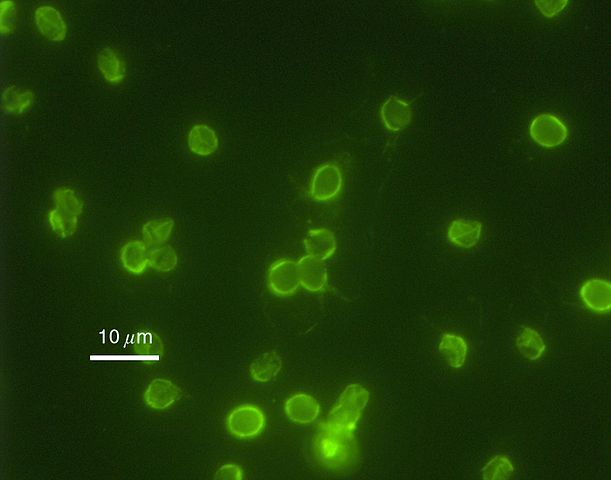

Cryptosporidium
Morphology, Microscopy, Tests, Infection/Treatment
Definition
Cryptosporidium is a genus of apicomplexan parasites that infect a wide range of vertebrates (humans included). Typically, the parasite infects the microvillus border of the gastrointestinal epithelium causing persistent diarrhea (Cryptosporidiosis). However, among immunosuppressed individuals, the infection may spread to other parts of the body (e.g. respiratory tract, pancreatic duct, stomach).
While the infection is asymptomatic in many animals (which then act as reservoirs), it can be life threatening among children, the malnourished and those with a weakened immune system.
Currently, about 39 species of the genus have been identified. Of these, about 20 species are known to cause gastrointestinal disease in human beings.
* The word Cryptosporidium originates from Latin word meaning underground spore.
Cryptosporidium parvum (C. parvum) is one of the leading causes of persistent diarrhea and thus the most studied and better understood species of the genus Cryptosporidium.
Some of the other members of the genus include:
- C. hominis
- C. bivis
- C. xiaoi
- C. ubiquitum
- C. andersoni
- C. baileyi
Classification
- Phylum: Apicomplexa
- Class: Sporozoasida
- Subclass: Coccidiasina
- Order: Eucoccidiida
- Suborder: Eimeriina
- Family: Cryptosporidiidae
Characteristics of Cryptosporidium
Generally, Cryptosporidium are ubiquitous in nature and can, therefore, be found everywhere (in different environments across the globe). They are also zoonotic and thus spread between animals and human beings.
Life Cycle
Like members of the genus Cyclospora, Cryptosporidium species also exhibit a monoxenous life cycle. As such, they complete their life cycle (both sexual and asexual stages) within a single host.
Cryptosporidium oocysts may be released into the environment along with the feces or other bodily secretions (E.g. respiratory secretions). These oocysts contain four sporozoites and represent the infective stage of the parasite and remain in the environment until they are ingested by the host.
Once ingested, the sporulated oocysts excyst in the gastrointestinal tract to release the sporozoites. In the gut, the sporozoites penetrate and infect epithelial cells (This is achieved through a form of motility know as gliding motility (circular and helical movements) using actin-myosin-tubulin) of the ileum where they are enclosed by a thin layer of the cytoplasm.
Here, a desmosome-like organelle (known as a feeder organelle) develops at the interface between the parasite and the cell cytoplasm of the host allowing for nutrient uptake.
Within the cells, asexual reproduction (multiple fission- Merogony) results in the formation of Type I meronts that rapture to release eight merozoites. The free merozoites then penetrate new cells where they undergo further multiple fission to produce new meronts. If not under control, it is thought that the cycle can continue indefinitely.
Through successive generations of merogony, Type I merozoites have also been shown to give rise to the second type of meront known as Type II meront.
Unlike Type I meronts, type II meront contains 4 merozoites that when released (and penetrate new cells), mature to form macrogametes and microgametes. Once they are well developed, microgametes penetrate the macrogametes to form the zygote.
An oocyst wall is then formed around the zygote as sporozoites are formed through meiosis (this process is known as sporogony). The oocysts are then released into the environment (in feces) allowing the cycle to continue.
Morphological Characteristics
The morphological characteristics of Cryptosporidium vary between the different stages of the parasite. The oocysts released into the environment are ovular in shape with a smooth surface. Although it has a thick wall that makes it resistant, it also has a cleft on one side that allows for sporozoites to be released during excystation.
These oocysts measure about 5×7um. Sporozoites, on the other hand, measure about 5×0.5um and are characterized by a rough surface and a pointed apical region as well as a rounded posterior. Trophozoites, on the other hand, measure between 1 and 2.5um in length and are characterized by a smooth surface and hood-like shape.
While Type I and Type II meronts vary in size (1.5 and 3.5um respectively), they are both characterized by an epicellular, smooth surface and the merozoites they produce are relatively similar in size (about 0.4×1um).
Type I merozoites have a rod-like shape with a pointed apical region and rough surface while type II merozoites are characterized by a round and rough surface. On the other hand, the microgametes formed from Type II merozoites measure about 0.1um with a spherical and rough surface while the macrogamont measure 4×5um with an ovular and rough surface.
Adaptations
In the environment (outside the body of the host), the oocysts are surrounded by a thick wall that allows them to survive various unfavorable conditions before then are ingested by a favorable host. This also makes it possible for the parasite to survive in various environments across the globe from where they can infect hosts once ingested.
In the gut, the development of Cryptosporidium has also been shown to occur rapidly with each new generation developing and maturing within a period of about 12 hours. This rapidity of life cycle, in addition to autoinfective cycles caused by thin-walled oocysts in the gut (which make up about 20 percent of oocysts in infected individuals), can result in high numbers of the parasite colonizing the intestinal tract within a few days if not controlled.
For those with a compromised immune system, the infection may also spread to such secondary sites as the respiratory tract and stomach which can be fatal.
* Even without exposure to exogenous oocysts (Cryptosporidium oocysts from the environment) Type I recycling merozoites, as well as the thin-walled oocysts, can cause the infection to persist within a host.
* Only a few (about 10 oocysts) are required to cause watery diarrhea.
* Cryptosporidium oocysts are released into the environment in large numbers and can survive for extended periods of time.
One of the other important adaptation of Cryptosporidium species is the fact that along with the host, they evolve and become adapted to given animals. Based on a number of studies, this has been shown to help them gradually develop host specificity. For instance, many genotypes of the species C. canis have been shown to infect and become adapted to foxes, dogs, and coyotes (animals with some similar characteristics).
A number of Cryptosporidium species have been shown to be host specific and are therefore adapted to given hosts. However, others can be spread from animals to human beings (zoonotic species) thus contributing to human cryptosporidiosis. This has been particularly shown to affect some farmers and slaughterhouse workers who are often in contact with different types of animals.
* As with human beings, not all infected animals exhibit such clinical signs as diarrhea.
Apart from transmission through animal contact, some of the other common modes of transmission include:
- Contaminated water
- Contaminated foods
- Dairy effluents
- Transmission through contact with infected individuals (such cases have been identified in such institutions as day-care centers)
Pathogenesis
The earliest cases of human cryptosporidiosis were reported in the mid-1970s among a number of patients who exhibited severe watery diarrhea. While abdominal pain and diarrhea are the most common symptoms of the disease, some of the other symptoms include vomiting, low-grade fever as well as nausea. The infection may also result in general malaise, myalgia, headache, as well as anorexia.
Here, severity is largely dependent on the type of Cryptosporidium as well as host factors. For instance, as compared to immunocompetent individuals, immunocompromised patients (e.g. HIV/AIDs patients) are likely to be more affected. If left untreated, among such patients, the infection can cause dehydration and wasting which is life-threatening.
Using two classes of proteins (mucin-like glycoproteins and thrombospondin-related adhesive proteins) Cryptosporidium are able to adhere to, invade and establish themselves within the epithelial cells of the ileum. As they reproduce and increase in numbers, the parasite causes cell damage characterized by the disruption of cell junctions, reduced barrier function and ultimately cell death.
Although the mechanism through which they actually cause damage to the cells is still unknown, researchers have suggested this to be as a result of a number of molecules released by the parasite (e.g. hemolyns, phospholipases, and proteases).
Whereas proteases support the life cycle of the parasite by promoting invasion into host tissues as well as allowing the parasite to evade host immunity, Hemolysin H4 has been shown to contribute to the disruption of the cell membrane which not only promotes cell invasion, but also disrupts normal cellular functions.
* Cryptosporidium parasites (e.g. C. parvum) do not penetrate deep tissue.
Depending on the host, Cryptosporidium infection may cause:
- Villous atrophy
- Crypt hyperplasia
- Inflammation of the epithelial layer- characterized by infiltration of various immune cells
* Through a combination of these factors, the parasite causes increased permeability of the intestine and malabsorption.
Detection and Diagnosis Tests
Currently, a number of techniques are used to detect the presence of Cryptosporidium (particularly C. parvum) in patients. This section will focus on acid-fast staining and antigen test; these being some of the most commonly used methods.
Acid-Fast Staining
Ziehl-Neelsen Stain
One of the most commonly used acid-fast staining technique is the Ziehl-Neelsen Stain method. As an acid-fast stain method, it's used to detect organisms capable of retaining the primary stain after decolorization.
Requirements
· 0.3 percent Carbol Fuchsin
· 25 percent Sulphuric acid (decolorizing agent)
· Secondary stain/counter-stain" Methylene blue
· Clean splints
· Compound microscope
· Tap water
· Drying rack
· Sample
· Bunsen burner
Procedure
· Using a splint, obtain a small amount of the sample and make a thin smear on a clean glass slide
· Pass the slide over a flame a few times (about 3 times) to heat fix - Do not overheat the smear
· Place the slide on a staining rack and flood with carbol fuchsin - The slide may be passed over the flame until fumes appear but without boiling
· Allow the slide to stand for about 5 minutes
· Rinse/wash the slide with smooth-running water
· Pour sulphuric acid on the slide for about 1 minute - This step should reveal a pinkish color
· Wash/rinse the slide with water (gently)
· Flood the slide with methylene blue and allow to stand for about 2 minutes
· Wash/rinse the slide with water and wipe off excess water
· Allow the slide to air-dry before examining under the microscope
· Lastly, examine the slide under the microscope using 100x oil immersion objective
Observation
When viewed under the microscope, the oocysts (which appear spherical in shape) will appear pink/red in color.
Modified Kinyoun Acid-Fast Stain Technique
Apart from Ziehl-Neelsen modified acid-fast stain method, modified Kinyoun acid-fast stain technique can be used. As compared to the former, this method does not require heating to fix.
Requirements
· Kinyoun carbol fuchsin
· 1 percent sulfuric acid
· Methylene blue
· Absolute methanol
· Microscope coverslips
· Sample
· Staining rack
Procedure
· Using a splint, smear a small amount of the sample on a slide and make a thin smear (thin enough to see through)
· Allow the smear to air-dry
· Add a few drops of absolute methanol on to the sample to fix for about 1 minute
· Flood the slide with the primary stain (Kinyoun’s carbol fuchsin) and allow it to stand for about 5 minutes
· Gently rinse the slide with 50% ethanol and then gently rinse with water
· Decolorize the sample using 1 percent sulfuric acid for about 2 minutes
· Again, gently rinse the slide with water and drain excess water
· Flood the slide with methylene blue and allow it to stand for about 1 minute
· Place the slide under the microscope and observe using 100x oil immersion objective
Observation
When viewed under the microscope, oocysts will appear pink/red in color.
Antigen Test
Today, an antigen test is the method of choice for the diagnosis of cryptosporidiosis. This is largely because of the fact that the technique provides higher sensitivity as compared to acid-fast staining methods.
Some of the tests (antigen tests) available for use include:
· Antibodies labeled with fluorescent reporters - For this technique, mAbs (Monoclonal antibodies) are used to detect epitopes present on the oocyst surface. Typically, the Monoclonal antibodies (C-mAbs) have been shown to react to multiple stages of the life cycle within the cells of the ileum with different species and genocytes having exhibiting different fluoresce intensities (this is dependent on oocyst epitope expression of the organism).
· Antibodies labeled with enzyme reporters - Currently, some of the kits available for antigen detection using antibodies labeled with enzyme reporters include Enzyme Immunoassay (EIA) and Immunochromatographic (IC). Using EIA kits (in microplate format), which has 93 to 100 percent sensitivity and specificity; it's possible to detect Cryptosporidium antigens in such fresh or preserved samples.
Prevention and Treatment of the Infection
Preventive measures
Cryptosporidium infections present a major public health problem in both the developing and developed nations. As a result of watery diarrhea caused by the infection, Cryptosporidium has also been shown to cause stunted growth of children, particularly in developing countries.
Apart from the public health problem, Cryptosporidiosis (especially in the event of waterborne outbreaks in developing countries) also has a negative economic impact amounting to tens of millions of dollars (due to medical costs and lost productivity). For this reason, it's important to implement preventive strategies in order to prevent or significantly reduce the rate of infections.
Waterborne transmission has been shown to be of the primary methods through which the parasite is spread. Given that Cryptosporidium species are able to survive water chlorination, flocculation and proper filtration of drinking is one of the best preventive measures. On the other hand, researchers are recommending a number of new approaches including reverse osmosis, radiation, and membrane filtration.
Some of the other methods that can be used to prevent new infections include:
· Proper management of sewage
· Washing hands with soap and warm water before eating
· Treating infected domestic animal to prevent transmission to human beings
Treatment options
Although there is a number of antiparasitic and antimicrobial agents in the market as a treatment options for cryptosporidiosis, they are aimed at relieving the symptoms and improving the immune response of patients rather than directly eradicating the parasite. Using such antiparasitic agents as paromomycin, the number of parasites can be slightly reduced.
Some of the other treatment options include:
· Anti-motility agents - Using such anti-motility agents as loperamide, intestine movement is reduced thus increasing fluid retention. This significantly reduces westerly diarrhea (the primary cause of dehydration and wasting)
· Anti-parasitic agents - Anti-parasitic drugs are beneficial for patients with compromised immune systems given that they attack and help reduce the number of parasites. Some of the most popular anti-parasitic drugs in the market today include Nitazoxanide and Azithromycin. By attacking the parasite, the drugs help relieve diarrhea.
· Antiretroviral therapy - This treatment option is meant to boost the immune system among HIV/AIDs patients. By improving the immune system the body can defend itself against the parasite.
Return to Parasite under the Microscope
Return from Cryptosporidium to MicroscopeMaster home
References
Alaa A. Ghazy, Sobhy Abdel- Shafy and Rafaat M. Shaapan. (2015). Cryptosporidiosis in Animals and Man: 1. Taxonomic Classification, Life Cycle, Epidemiology and Zoonotic Importance. Asian Journal of Epidemiology, 8: 48-63.
Lihua Xiao, Ronald Fayer, Una Ryan, and Steve J. Upton. (2004). Cryptosporidium Taxonomy: Recent Advances and Implications for Public Health. Clinical Microbiology Reviews.
Maha Bouzid, Paul R. Hunter, Rachel M. Chalmers, and Kevin M. Tyler. (2013). Cryptosporidium Pathogenicity and Virulence. Clinical Microbiology Reviews.
Richard L. Guerrant. (1997). Cryptosporidiosis: An Emerging, Highly Infectious Threat.
Saul Tzipori and Honorine Ward. (2002). Cryptosporidiosis: biology, pathogenesis and disease. Microbes and Infection 4 (2002) 1047–1058.
Links
http://www.med-chem.com/pages/lab_procedures/pdf/modified_kinyoun_cold.pdf
Find out how to advertise on MicroscopeMaster!
![Very high magnification micrograph of cryptosporidiosis (cryptosporidium infection). H&E stain. Colonic biopsy by Nephron [CC BY-SA (https://creativecommons.org/licenses/by-sa/3.0)] Very high magnification micrograph of cryptosporidiosis (cryptosporidium infection). H&E stain. Colonic biopsy by Nephron [CC BY-SA (https://creativecommons.org/licenses/by-sa/3.0)]](https://www.microscopemaster.com/images/Cryptosporidiosis_-_very_high_mag_-_cropped.jpg)




